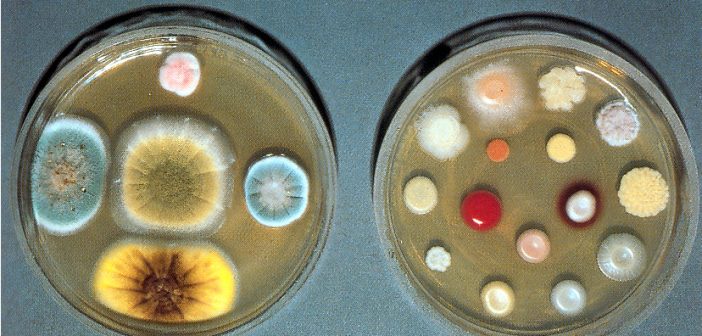

Ecco come i batteri acquisiscono la resistenza agli antibiotici
I patogeni gram negativi diventano insensibili agli antibiotici acquisendo i geni della resistenza dagli attinobatteri, che vivono nei suoli. Il processo avviene grazie a un trasferimento genico chiamato carry back, scoperto grazie a un nuovo studio condotto in Danimarca
www.lescienze.it
La resistenza agli antibiotici è un problema sempre più serio in tutto il mondo: esistono infatti ceppi di batteri che non possono essere eradicati, ponendo in serio pericolo la salute della persona infetta. Per trovare una soluzione, molti ricercatori stanno ora cercando di capire quale possa essere l’origine dei geni che conferiscono ai batteri la loro “immortalità”.
Un nuovo studio pubblicato su “Nature Communications” da Xinglin Jiang e colleghi della Novo Nordisk Foundation Center for Biosustainability – DTU Biosustain, presso la Technical University of Denmark, dimostra ora quella che per circa 30 anni è rimasta solo un’ipotesi: i geni della resistenza antibiotica hanno origine da una famiglia di microrganismi che vive nei suoli: gli attinobatteri.
In una serie di esperimenti, i ricercatori hanno scoperto che in una famiglia di patogeni, chiamati gram-negativi, molti geni della resistenza sono simili ai geni della resistenza che si trovano negli attinobatteri. In un caso in particolare, è risultata una corrispondenza del 100 per cento.

Attinobatterti in coltura (Credit: DTU/DTU Biosustain)
La scoperta non era facile da spiegare: come fanno batteri molto diversi dagli attinobatteri ad acquisire da essi i geni della resistenza antibiotica? Le analisi genetiche hanno permesso d’individuare un nuovo meccanismo chiamato carry back, durante il quale i patogeni gram-negativi iniettano il loro DNA negli attinobatteri, dove si ricombina con il DNA dell’ospite, che contiene i geni della resistenza antibiotica.
Morto l’attinobatterio, il DNA ricombinante viene rilasciato nell’ambiente. Infine, il DNA iniettato può agire come una sorta di colla, mediando l’acquisizione dei geni della resistenza da parte dei patogeni, grazie a un fenomeno chiamato trasformazione naturale.
Perché avvenga
il trasferimento è sufficiente che vi sia un’occasione di contatto tra i due batteri, per esempio in un allevamento di animali, o in un terreno in cui vengono abbandonati rifiuti ospedalieri non trattati. Una volta acquisiti i geni necessari, il patogeno può diventare resistente ed essere pericoloso per gli esseri umani infettati successivamente.
Il risultato dello studio potrebbe essere estremamente prezioso per trovare una soluzione al problema dell’antibioticoresistenza.
“Ancora non siamo in grado di fermare il processo di trasferimento genico, ma una volta che sono noti i geni che conferiscono ai patogeni la resistenza antibiotica è possibile in linea di principio sviluppare nuovi antibiotici con altre caratteristiche da cui i patogeni non possono difendersi”, ha concluso Tilmann Weber, autore senior dello studio.